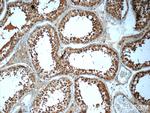
HYDIN Antibody in Immunohistochemistry (Paraffin) (IHC (P))
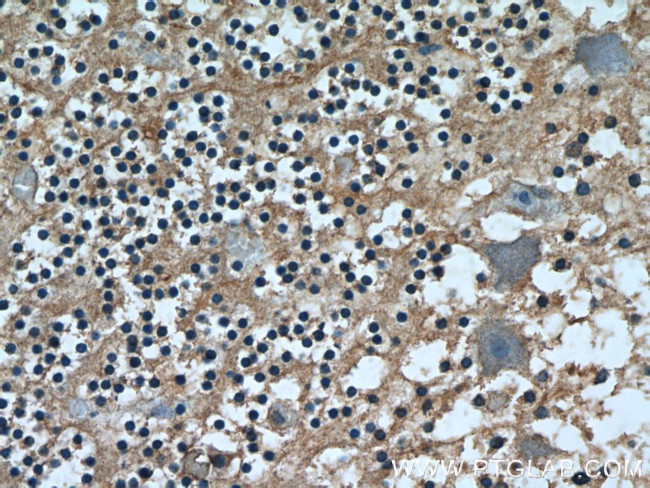
HYDIN Antibody in Immunohistochemistry (Paraffin) (IHC (P))

Search
Proteintech
HYDIN Polyclonal Antibody
{{$productOrderCtrl.translations['antibody.pdp.commerceCard.promotion.promotions']}}
{{$productOrderCtrl.translations['antibody.pdp.commerceCard.promotion.viewpromo']}}
{{$productOrderCtrl.translations['antibody.pdp.commerceCard.promotion.promocode']}}: {{promo.promoCode}} {{promo.promoTitle}} {{promo.promoDescription}}. {{$productOrderCtrl.translations['antibody.pdp.commerceCard.promotion.learnmore']}}

Please note: We are reviewing Western blot images included in the antibody testing data in our catalog, including those provided by third parties. Unless expressly labeled or annotated as “raw-unedited”, Western blot images included in the antibody testing data in our catalog may have been edited, optimized or otherwise adjusted for presentation.
产品信息
24741-1-AP
种属反应
宿主/亚型
分类
类型
抗原
偶联物
形式
浓度
规格
纯化类型
保存液
内含物
保存条件
运输条件
产品详细信息
Immunogen sequence: MTSRRLEES MGAVQMGLVN MFKGFQSKVL PPLSPKVVTE EEVNRMLTPS EFLKEMSLTT EQRLAKTRLM CRPQIIELLD MGETTHQKFS GIDLDQALFQ PFPSEIIFQN YTPCEVYEVP LILRNNDKIP RLVKVVEESS PYFKVISPKD IGHKVAPGVP SIFRILFTPE ENKDYAHTLT CVTEREKFIV PIKARGARAI LDFPDKLNFS TCPVKYSTQK ILLVRNIGNK NAVFHIKTCR PFSIEPAIGT LNVGESMQLE VEFEPQSVGD HSGRLIVCYD TGEKVFVSLY GAAIDMNIRL DKNSLTIEKT YISMANQRTI TIHNRSNIIA HFLWKVFATQ QEEDRE (22-366 aa encoded by BC028351)
靶标信息
Required for ciliary motility.
仅用于科研。不用于诊断过程。未经明确授权不得转售。
篇参考文献 (0)
生物信息学
蛋白别名: Hydrocephalus-inducing protein homolog
基因别名: HYDIN; HYDIN1; KIAA1864
Entrez Gene ID: (Human) 54768